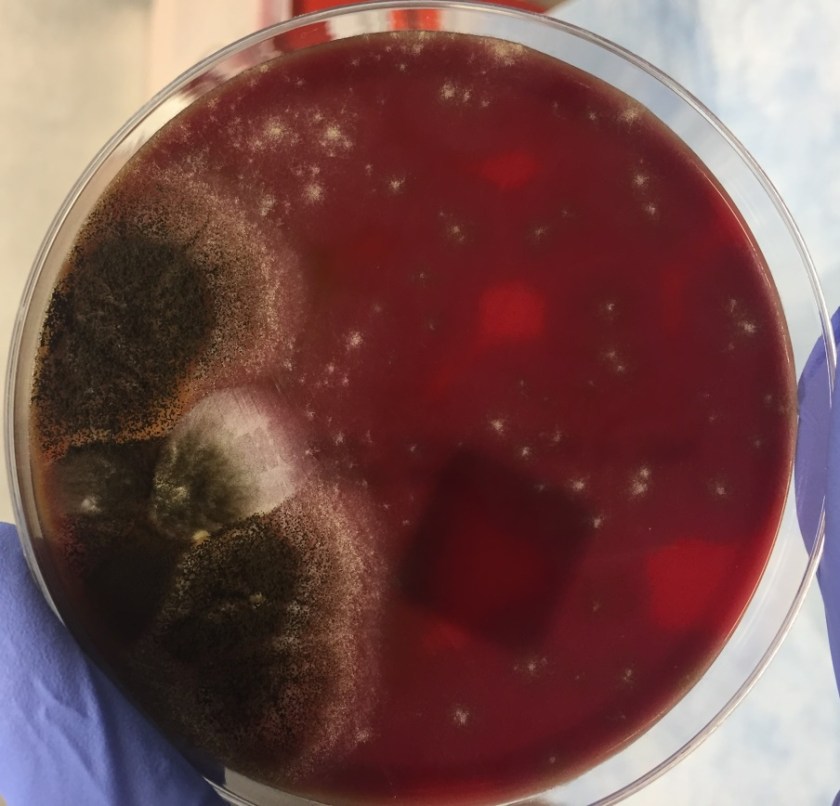
synrac1

Case History
A 55 year old female with a history of chronic obstructive pulmonary disease, alpha-1 antitrypsin deficiency, and current tobacco use was transferred to our hospital due to acute hypoxemic respiratory failure. She had a gradual six day onset of cough, fever, malaise, weakness, dizziness and wheezing. At the outside facility, she was hypoxic with an oxygen saturation of 67% at room air, hypotensive with a blood pressure of 80/50. She was intubated en route to our facility.
Labs were significant for a positive influenza B swab, leukopenia (WBC 1.2) with 59% bands, and acute kidney injury with a creatinine of 1.4 mg/dl and hyponatremia with a sodium level of 129 mEq/L. Blood cultures grew Streptococcus pneumoniae, sensitive to ceftriaxone. At our facility, she was started on ceftriaxone and azithromycin. She completed 14 days of ceftriaxone; however, she continued to have intermittent fevers above 38 degrees Celsius. Due to the patient’s continued fever, infectious work up was initiated and showed Candida in her urine and HSV lesions on her lips. She was started on a 14 day course of fluconazole and valacyclovir.
Tracheal aspirates on two occasions were also cultured and grew mixed gram positive and negative organisms as well as Syncephalastrum species. Four weeks after being admitted to our facility, she developed a right-sided hydropneumothorax in which 500 mL of exudative fluid was drawn and subsequently cultured. These cultures also grew Syncephalastrum species as well as Staphylococcus epidermis.

Discussion
Syncephalastrum racemosum is thought to be the only species out of the two Syncephalastrum species known to cause mucormycoses in humans (1). The only proven reported cases of infection have been due to percutaneous inoculation after trauma, however whether this is due to low pathogenicity, no case reports, or interpretation as a contaminant remains a mystery (1).
Syncephalastrum is a saprophytic fungus isolated throughout the world particularly in environments with decaying organic matter (1, 2). It is found in low levels in the air and has been reported to colonize both immunocompromised and healthy individuals after natural disasters (3).
Diagnosis of Syncephalastrum can be made by visualizing pauci-septate, ribbon-like mycelium and a merosporangial sack surrounding sporangiospores from the cultures using a lactophenol cotton blue mount preparation (1). Caution should be used in distinguishing Aspergillus niger from Syncephalastrum using a direct KOH mount due to the similarities in their fruiting bodies (1). On a petri plate, it begins as fast growing white fluff and then turns dark gray to almost black with the reverse side being white (4).
References
- Gomes MZ, Lewis RE, Kontoyiannis DP. Mucormycosis caused by unusual mucormycetes, non-Rhizopus, -Mucor, and -Lichtheimia species. Clin Microbiol Rev. 2011;24(2):411-45.
- Ribes JA, Vanover-sams CL, Baker DJ. Zygomycetes in human disease. Clin Microbiol Rev. 2000;13(2):236-301.
- Rao CY, Kurukularatne C, Garcia-diaz JB, et al. Implications of detecting the mold Syncephalastrum in clinical specimens of New Orleans residents after Hurricanes Katrina and Rita. J Occup Environ Med. 2007;49(4):411-6.
- Larone DH. Medically Important Fungi, A Guide to Identification. Amer Society for Microbiology; 2011.
-Angela Theiss is a pathology resident at the University of Vermont Medical Center.

-Christi Wojewoda, MD, is the Director of Clinical Microbiology at the University of Vermont Medical Center and an Associate Professor at the University of Vermont.